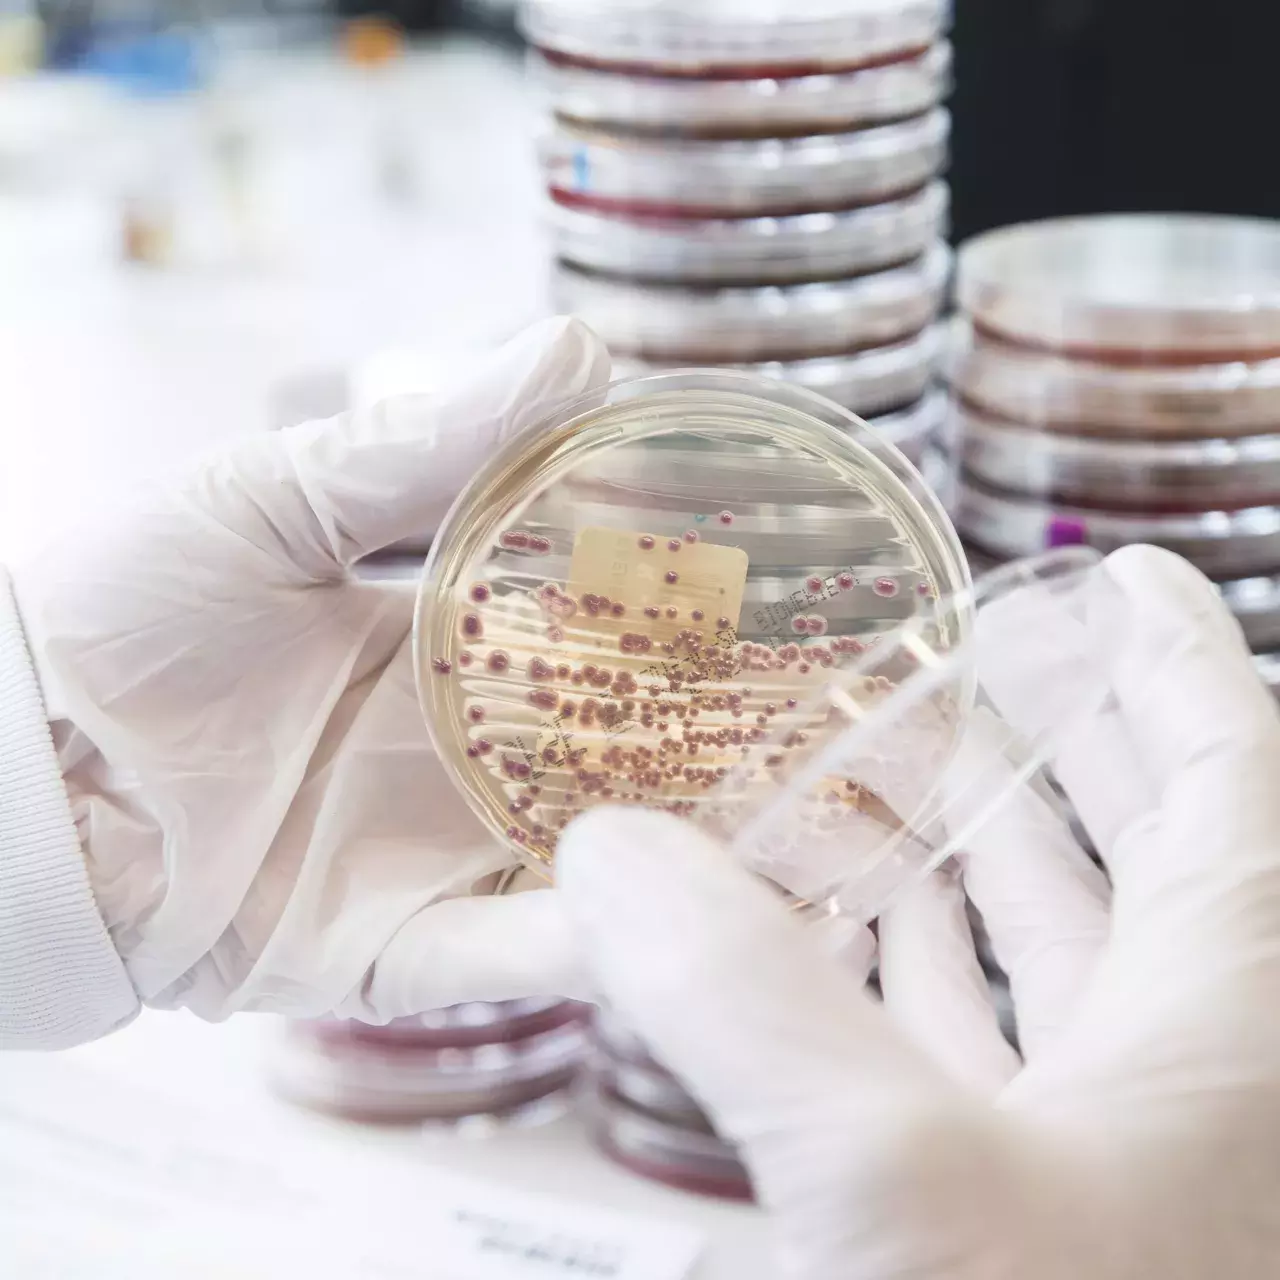
multiresistance bacterienne aux antibiotiques

Chercher
Chercher


Etude préclinique
Microbiote et cancer du foie, l’impact de l’obésité maternelle
17e édition
Journée de la recherche clinique 2024

Santé mentale
À Genève, un jeune sur sept touché par des idées suicidaires

Santé cardiovasculaire
Après un infarctus, le «binge drinking» est dangereux

Avancée
Culture de minitumeurs pour mieux soigner le cancer du poumon
Situation alarmante
Antibiorésistance en Afrique, une menace grandissante pour les enfants

Thérapie innovante par radioligands
Une avancée majeure dans le traitement des tumeurs cérébrales et digestives

Consentement général
Comprendre la recherche clinique dès le plus jeune âge
Vulgarisation scientifique